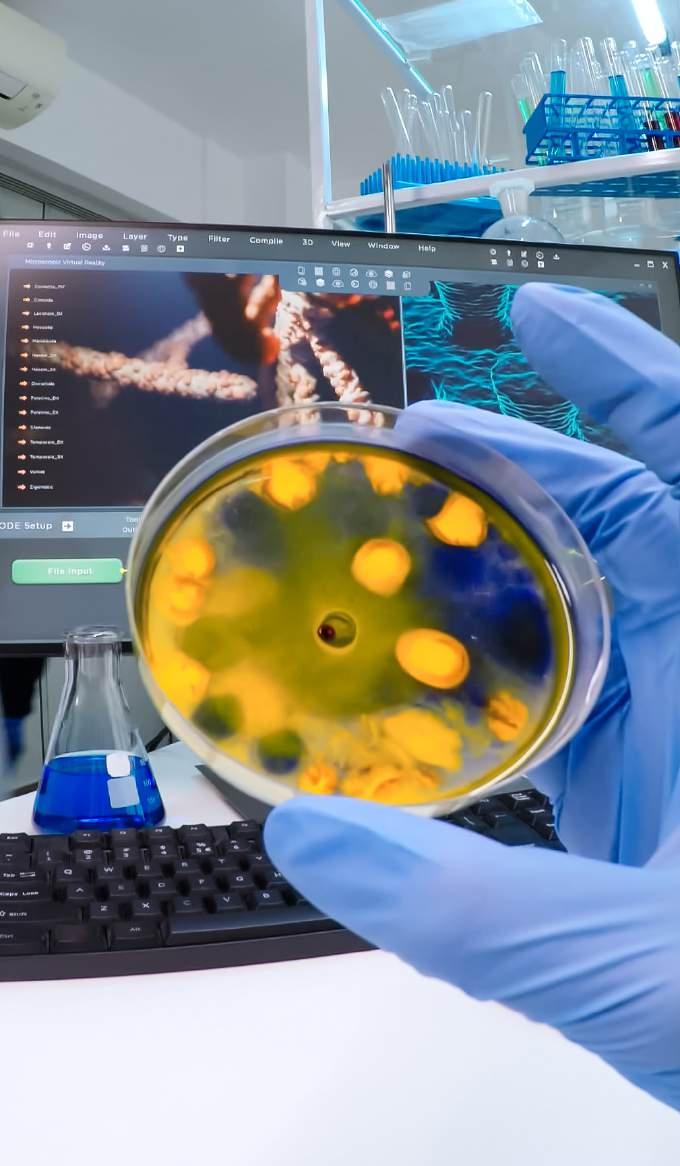

2025 highlights ASU research is for you



![]()

2025 highlights ASU research is for you



At Arizona State University, research serves the public good. Guided by accountability to the communities we serve, Knowledge Enterprise leads ASU’s efforts in discovery and innovation that create lasting value.
To do so, we listen to our communities to find out what matters most and take action to solve the challenges they face. Research at ASU makes a difference in many ways:
• New therapies that promote recovery from disease
• Reliable energy systems that keep lights on and bills low
• Effective water conservation that ensures our future in the desert
• Advanced technologies that protect national security
• Early wildfire detection that prevents destruction
• A thriving business environment and skilled workforce that support Arizona’s economic growth
The issues facing society are complex, urgent and evolving. They require collaboration across sectors and disciplines. In addition to listening, ASU leads in identifying grand challenges and bringing people together to create meaningful solutions.
This year, ASU reached $1 billion in annual research expenditures. These funds represent investments in projects that serve the public at local, state and national levels.
The ASU SolarSPELL Initiative, named one of TIME’s 2025 Best Inventions, is an example of our impact. SolarSPELL’s solar-powered digital libraries, created with students in engineering, design and education, deliver access to learning in remote regions with no electricity or internet.
Former ASU faculty member Omar Yaghi received the 2025 Nobel Prize in Chemistry for his pioneering work on metal-organic frameworks, which he began at the university. His discoveries could help us leverage hydrogen energy, harvest precious water or reduce carbon in the atmosphere. His achievements demonstrate how foundational research can transform the world.
ASU’s partnerships with government and industry continue to expand opportunities for collaboration. Applied Materials, the nation’s largest producer of semiconductor manufacturing equipment, opened its Materialsto-Fab Center at ASU’s Research Park. The center serves as a research and development hub for next-generation semiconductor technologies.
Looking ahead, ASU is pursuing new areas of research aligned with national priorities.
Artificial intelligence continues to boost innovation by offering new insights and capabilities that help us solve problems faster. Creating ethical frameworks, protecting national security and finding new ways to put AI in action will be priorities going forward.

Researchers are also exploring how food can function as medicine, using nutrition to prevent or manage diseases; how to ensure a robust supply of the critical minerals our industries depend on; and how to solve problems too complex for today’s technologies with quantum science.
These fields represent opportunities to shape the future, improve lives, strengthen communities, generate new business , and position Arizona and the nation for leadership in a rapidly changing world.
Although Knowledge Enterprise focuses on research, ASU’s most important product is its students. More than 194,000 students benefit from courses, mentoring and hands-on learning opportunities that prepare them for success. Our workforce development efforts provide lifelong learning opportunities and help keep our state and nation competitive.
In a time of uncertainty, we remain dedicated to our purpose. Research is a stepping stone toward the future we envision and the goals we share. It creates solutions that serve our communities and the world.
I encourage you to continue pushing the boundaries of knowledge. I am proud of ASU’s impact, and I am honored to lead Knowledge Enterprise and excited for what is to come. Let’s continue to change the way the world solves problems.

Sally C. Morton Executive Vice President ASU Knowledge Enterprise
One can see ASU’s impact all around Phoenix and the state — driving innovation and producing a top-notch workforce that can take on the challenges of today and the future. I’ve said it before, and I’ll say it again: When we’re working to secure investment in our economy and locate the top companies in Phoenix, ASU is our secret weapon in closing the deal.”
3,695
ASU students engaged in paid research positions
80 179 161
2,156
in numbers 330 198 21 65
Over the last 20 years, ASU has contributed expertise to 51,902 policy documents across 136 countries, including 17,050 in the U.S. Topics include economics, health, sustainability and the natural environment, education, and more.
Overton Index
nonprofit sponsors of ASU research in 2025
industry sponsors in 2025, including Applied Materials, Labcorp, Intel and Nestlé
federal agency sponsors in 2025
active international project sponsors
#1 in the U.S. and top 10 worldwide for global impact in research, outreach and stewardship, ahead of MIT and Penn State, according to Times Higher Education.
In FY 2025, ASU innovators working with Skysong Innovations generated:
invention disclosures
U.S. patents
new startup companies
licensing deals
Financial Times ranks the W. P. Carey School of Business #17 in the world and #3 among U.S. public business schools for business school research impact, ahead of Duke University, London Business School, UT Austin and Washington University in St. Louis.
Top 10 among universities worldwide for U.S. patents, along with MIT, Purdue and Stanford, according to the National Academy of Inventors.
ASU is one of the fastest-growing research e nterprises in the United States, increasing its research expenditures more than seven times since 2002
We’re fortunate to have a world-class university like ASU partnering in Arizona’s economic success. From programs that provide in-demand training to cutting-edge research and facilities that foster innovation, ASU is central to growing economic opportunity statewide.”
Sandra Watson President and CEO Arizona Commerce Authority
In fiscal year 2024, ASU exceeded $1 billion in annual research expenditures for the first time. This number reflects research funding used to advance knowledge and technologies that improve human well-being.
$1.003B
National rankings by research expenditures






Deaths from leading killers — including heart disease, stroke, cancer and HIV — declined significantly between 2000 and 2019. But deaths from Alzheimer’s disease in the U.S. increased by about 145%.
Association

ASU researchers have introduced a new idea that could reshape how doctors and scientists understand Alzheimer’s disease.
Their work focuses on stress granules, small clumps of proteins and RNA inside cells.
Normally, stress granules form when cells are under threat, helping them cope with temporary problems. After the stress passes, the granules usually disappear. But the ASU team found that in Alzheimer’s, these granules linger far too long. Instead of protecting cells, they start to cause harm.
Stress granules block the system that moves molecules between the nucleus, where DNA is stored, and the cytoplasm, where proteins are made. When this system fails, thousands of genes no longer work correctly. As a result, brain cells lose the ability to make energy, build proteins and maintain connections that allow neurons to communicate with one another.
This theory is powerful because it brings many different features of Alzheimer’s under one explanation. For decades, scientists have studied the disease by looking separately at amyloid plaques, tau tangles, inflammation or cell breakdown. But whether these were connected was a mystery. The new model suggests that stress granules could be the culprit, damaging many different parts of the brain over time. It also suggests the disease begins years before symptoms like memory loss appear, offering a chance for much earlier detection.
If proven, the idea could completely change the way Alzheimer’s is treated. Most current therapies focus on easing symptoms rather than stopping the disease itself. But if scientists can find a way to target stress granules early, they might be able to delay or even prevent Alzheimer’s.
The potential benefits are enormous. Doctors may be able to look for small, early changes in brain cells that signal Alzheimer’s long before it becomes severe. This would make diagnoses more accurate and give families more time to plan and seek care. New therapies could protect brain health longer, allowing people to stay independent and maintain quality of life for additional years.
On a global scale, the effects could also be dramatic. In 2019, the societal cost of dementia was estimated at $1.3 trillion, and that number is expected to climb to $2.8 trillion by 2030. Finding ways to delay or prevent Alzheimer’s could ease human suffering while also lowering this heavy financial burden for societies everywhere.
Although the theory still needs more research, the ASU team’s work offers hope. By uniting many mysteries of the disease into one framework, the researchers may have opened the door to earlier detection, better treatments and a brighter future for millions worldwide.

of Americans will be diagnosed with cancer in their lifetime.
American Cancer Society 40%


ASU researchers and partners at the University of Arizona are developing a promising new way to fight cancer. The team designed a peptide, called peptide 2012, that stops cancer cells from attaching to their surroundings. Without this ability to anchor themselves, the cells cannot grow, spread or survive. This is important because cancer’s ability to spread is what makes it so dangerous.
Traditional treatments, like chemotherapy or kinase inhibitors, often harm healthy cells as well as cancer cells and come with nasty side effects. The new peptide offers a more
precise approach. It targets only cancer cells, leaving healthy tissue unharmed. In lab experiments with mice, peptide 2012 cut tumor growth by 80%. Even more encouraging, the treatment showed no toxic effects, making it safer than many existing therapies.
The key lies in how the peptide disrupts a protein called focal adhesion kinase, or FAK. Cancer cells rely on FAK both to send growth signals and to form the scaffolding they need to hold on to and survive. Earlier drugs tried to block FAK’s signaling function, but cancer cells found ways to
keep spreading. Peptide 2012 goes further by stopping FAK from partnering with another protein called paxillin. Without that connection, cancer cells can no longer cling together, and they self-destruct.
The team is now preparing for clinical trials. If successful, peptide 2012 could bring more effective treatments for tough cancers like melanoma, breast, pancreatic and lung cancers. One day, we may have cancer therapies free from harsh side effects.
Dr. John Shufeldt, an emergency medicine physician, health entrepreneur and ASU alum


A nine-figure gift from emergency medicine physician and entrepreneur John Shufeldt will establish ASU’s new medical school, the John Shufeldt School of Medicine and Medical Engineering
In addition to the gift — the second largest in university history — ASU received preliminary accreditation from the Liaison Committee on Medical Education in October. It’s an important milestone that will allow the school to begin recruiting its first class of students to start in the fall 2026 semester.
The John Shufeldt School of Medicine and Medical Engineering, together with primary clinical affiliate HonorHealth, will train students to blend multiple disciplines — medicine, engineering, technology and humanities — in order to create health care leaders with a strong sense of innovation and problem-solving.
The new medical school is one part of ASU Health, which is creating new schools, connecting existing ones and leveraging the entire university to focus on the health needs of the state and the nation.

There are no recorded cases of cancer in sponges. ASU scientists found that one type of sponge even survived radiation that would instantly kill a human — without any long-term damage.
AI in action

An AI tool called Ark+ will help doctors interpret chest X-rays more accurately. ASU researchers developed the AI model, training it with over 700,000 medical images from around the world, along with detailed physician notes. This approach allows Ark+ to recognize common, rare and emerging diseases with higher precision than existing tools. The researchers made the software open and shareable in the hope that hospitals and scientists everywhere could use it. Ultimately, the team wants its tool to improve patient care, even in underserved areas. Ark+ can also be used for other medical imaging, like CT and MRI scans. The innovation could make diagnoses faster, reduce errors and expand access to advanced medical technology for people worldwide.

The ASU College of Health Solutions launched the nation’s first online master’s degree program in cytology through a partnership with Labcorp and InStride. The program addresses a serious shortage of specialists who play a critical role in diagnosing cancer and other diseases. By combining online coursework with supervised, hands-on lab training, it allows students already working in clinical laboratories to advance their skills without leaving their jobs. This innovative approach provides nationwide access to high-quality training, especially in regions lacking cytology programs. Graduates will help meet growing health care demands, strengthen the diagnostic workforce and improve early disease detection. The partnership also creates a model for future academic-industry collaborations that expand opportunities and improve patient care.
“Given the rapid advancement in diagnostics testing, including in cytology, Labcorp’s collaboration with ASU to create dynamic and innovative learning solutions in areas like cytology enables our employees to remain at the forefront of cuttingedge science.”
Jon Meltzer Senior Vice President of Esoteric Business and Diagnostics
Labs, Labcorp

A new ‘gold standard’ diagnostic
Two dollars, one drop of blood or saliva, and 15 minutes — thanks to a new tool developed at ASU, that may be all it takes to diagnose a variety of diseases in the future.
The researchers showed their test can detect the virus that causes COVID-19 with pinpoint accuracy, clearly distinguishing it from other infections. The technology could also be used for illnesses such as Ebola, HIV, Lyme disease and others.
The device, called NasRED, uses tiny gold nanoparticles to identify extremely small amounts of diseaserelated proteins. It is roughly 3,000 times more sensitive than current lab techniques, similar to detecting a single drop of ink in 20 Olympic swimming pools.


In places where access to labs and trained staff is limited, NasRED offers a portable, affordable option that can be used almost anywhere. By spotting infections very early, it gives health workers the chance to treat patients before illnesses spread or become deadly. Fast, reliable detection could also help stop outbreaks before they spiral into public health crises.
Unlike PCR or ELISA tests that require expensive machines, NasRED is compact and simple to use. Its design is modular, meaning it can be adapted quickly to identify a wide range of diseases. Researchers have already shown it can detect not
just infectious agents, but also proteins linked to cancer and Alzheimer’s. That adaptability makes the technology a versatile platform for the future of health care.
The device is also significantly faster and more efficient than current standards, needing only a fraction of the sample volume and delivering results up to 30 times faster. With further development, it could even become a convenient at-home test.
NasRED represents a major leap forward for diagnostics worldwide. By making accurate testing fast, cheap
and accessible, it has the potential to save millions of lives, reduce health care costs, and strengthen global efforts to manage everyday illnesses and emerging threats.


Applied Materials, the largest U.S. maker of semiconductor equipment, is investing in ASU to advance microelectronics and train the next generation of engineers. The company is funding faculty research, supporting scholarships and helping build stateof-the-art facilities.
We’re looking for that moonshot. We want to partner with academia on developments that are five to 10 years out.”
The investment also directly benefits students. Applied Materials launched an endowed scholarship that supports engineering majors and hosted the first Applied Materials Innovation Day to connect students with industry experts. These opportunities provide hands-on learning, networking and career pathways in a growing field.
$200B+
in private investment in Arizona related to semiconductors in the past five years
ASU researchers are working on projects that explore new materials and manufacturing techniques. Ideas include using two-dimensional materials for better energy flow, gallium nitride for high-performance electronics and AI models to streamline production. These advances could lead to breakthroughs in computing, artificial intelligence and clean energy technology.
Vik Banthia Vice President of Front-end Products and Treatments in the
Semiconductor Products Group, Applied Materials
In October, Applied Materials and ASU officially opened the Materials-to-Fab Center, a $270 million research, development and prototyping facility at the ASU Research Park’s MacroTechnology Works facility. As a collaborative environment where faculty, students and industry can work together, the facility strengthens Arizona’s role as a semiconductor hub, drives innovation and builds a skilled workforce for the future.

Workforce development
ASU’s leadership in semiconductor innovation was on display at SEMICON West, the nation’s largest microelectronics trade show. This year it took place in Phoenix for the first time — a testament to Arizona’s growth as a chip-making powerhouse. The event showcased how ASU’s research and education efforts are fueling job creation, technological advancement and economic growth in one of the world’s most critical industries.
Partnership
ASU faculty, staff and students now have unprecedented access to nextgeneration AI computing power. Through a groundbreaking donation from Intel of 1,800 Gaudi2 AI accelerators, ASU has greatly expanded its AI research capacity. The new accelerators are housed across 200 servers, including locally at DCX, creating a secure, highperformance environment designed specifically for research, innovation and discovery. The gift places ASU among a small group of universities with enterprise-scale AI computing power.






Chip production could soon be cheaper, safer and better for the planet, thanks to a new effort by ASU and partner Cargill Bioindustrial. The project focuses on Cargill’s Priamine™, a plant-based material made from natural fatty acids that could form a new type of plastic. Researchers are testing how it might be used in electronics like smartphones, laptops and electric cars. By studying how this material works at the molecular level, the team hopes to design new high-performance plastics that can be
“This partnership empowers Cargill Bioindustrial to deliver high-performing, biobased innovations that meet the evolving needs of our customers in this rapidly growing market.”
Bryan Danek

Global Business Director of Coatings and Polymers, Cargill Bioindustrial
reused in future products. This effort could reduce the chip industry’s strain on natural resources, cut costs and create new options to recycle valuable materials.

Workforce development
Engineering graduate students are preparing for careers in the growing semiconductor industry with a new class that uses extended reality technology.
The course, called Metrology for Semiconductor Devices, allows students to step into a virtual lab environment where they can explore the tools and processes used to make microchips. Normally, gaining this experience would require access to expensive and highly

By 2030, there is projected to be a shortage of 67,000 workers in the semiconductor industry.
Semiconductor Industry Association
controlled clean rooms, which are not easy for large groups of students to enter. With augmented reality headsets, learners can interact with detailed 3D models of machines and materials right in the classroom.
The program also sets the stage for other engineering courses to adopt immersive teaching methods, giving students across disciplines more interactive ways to learn.

Arizona is investing in new technology to better prepare for disasters like wildfires, public health emergencies and extreme storms. The Arizona Board of Regents awarded $1.7 million to the Arizona Department of Emergency and Military Affairs. As part of the grant, a team of ASU experts will build AI-powered software that helps the state predict and manage emergencies.
The goal is to prevent cascading disasters, where one event triggers a chain of problems — for example, a fire that leads to damaged roads, power outages, hospital overloads and food shortages. By analyzing huge amounts of past disaster data, the AI model will calculate the likelihood of future events. This gives emergency planners the ability to pre-position resources, reduce risks and respond faster when crises hit.
ASU experts are combining computer science and machine learning with geospatial insights.
Their work will produce software that shows not just when a disaster may happen but also where it will strike and which communities will be most vulnerable. That means doctors, firefighters and relief teams will have clearer guidance on where to focus their efforts.
The ASU team will work closely with DEMA to ensure the new AI tools integrate smoothly into its existing systems so that they are ready to use.
Faster, more reliable information will help save lives, protect infrastructure, reduce economic losses and make sure resources are used efficiently. In the face of growing environmental and societal challenges, ASU is applying cutting-edge research to safeguard Arizona communities and strengthen resilience.

For decades, the military has evaluated teams in training through checklists and observations. But these methods can miss important details. ASU is leading a DARPA program to develop more reliable ways to measure team performance. The project focuses on U.S. Marine Corps fire support teams, which have to work together on complex, high-risk missions.

ASU researchers created the Bio-Behavioral Team Dynamics Measurement System, which uses sensors to monitor brain activity, breathing, heart rate, eye movement and verbal communication during training exercises. By analyzing this data, the system can objectively measure how well a team adapts to stress, recovers from unexpected challenges and works together under pressure.

With this technology, training programs are faster and more effective, which improves the combat readiness and safety of service members and reduces training costs.
The next phase of the program will explore how well this evaluation method works in other contexts, such as predicting the performance of air combat teams.
By providing accurate, scalable measures of team effectiveness, ASU’s research supports stronger military preparedness, enhancing teamwork in settings where lives and critical missions are on the line.
ASU is developing an AI program that could transform how the world responds to pandemics and biothreats. The system, called Network of Optimal Dynamic Energy Signatures (NODES), is designed to predict the function of hundreds of millions of proteins in just an hour. Instead of still images, the program captures how proteins move and change shape to

deliver more accurate insights. This speed and precision will be critical in moments of crisis, from identifying potential bioweapons to quickly responding to disease outbreaks. Beyond defense against biowarfare, NODES could also improve drug discovery, open new treatment options for complex diseases and reduce risks in biotechnology.
Powerful processors built at ASU will improve communications for national defense, including in space. These sustainable microchips could also free everyday consumers from mandatory device upgrades.
Two DARPA-funded projects led to two chips that balance power efficiency with the ability to talk across a wider range of frequencies. The research team is now testing prototypes from both projects.
The first project, called DASH, is part of DARPA’s Domain-Specific System on Chip program. It focuses on radio frequency communications and allows for capabilities like integrated sensing and communications.
The second project, COCHON, is part of DARPA’s Space-Based Adaptive Communications Node program. It applies the same principles from DASH to laser-based, or optical, communications. It’s especially useful for relaying data between satellites.
The Department of Defense uses a wide range of radio frequencies for secure communications. Typically, a low-power radio could only use one type of frequency. With the DASH chip, one radio can cover multiple frequencies while using less power — helping the DOD adapt to changing conditions.
The DOD also needs to connect with more satellites — its own as well as commercial ones. The COCHON chip will make it easier to use all available
resources and ensure it can talk to the next generation of satellites as well.
While the government funded these projects to meet defense needs, the chips have so many practical uses that they could eventually reshape consumer technology. Such spillover benefits are a common outcome of federally funded university research.
The COCHON chip has the potential to provide the embedded processing capabilities needed for an even wider range of applications — from 6G to flying cars, according to the lead researcher.
Meanwhile, the DASH chip could help solve everyday problems, like poor cell service in rural areas or emergency communications when traditional cell service is down. The flexibility allows phones to switch to longer-range frequencies when needed.
The DASH chip would also let us update our device capabilities, like adding 6G to a 5G phone, without replacing the device itself. That would mean no more of those costly mandatory upgrades.
Due to the special equipment needed, the team worked with Global Foundries to make test versions of the DASH and COCHON chips. The researchers have been testing the DASH chip since early 2025. They received the COCHON test chip in the fall. Their next steps will include testing the COCHON chip and looking for commercialization opportunities for the DASH chip.


New materials are needed throughout the aerospace and defense industries — think of the strength, durability and heat resistance needed for high-speed flight or long-range weaponry.
ASU researchers, working with the U.S. Army Research Laboratory and colleagues from other universities, developed a new copper alloy that delivers those sought-after features.
The alloy combines copper, tantalum and a small amount of lithium. Standard copper alloys weaken at high temperatures,
but this new material keeps its structure and strength even after long exposure.
The discovery opens new avenues for the development of next-generation copper alloys for applications in aerospace, energy and defense industries. Potential uses include heat exchangers, high-performance electrical components, weaponry and structural materials that require durability in extreme conditions.



Mars, say ‘cheese’!
En route to Jupiter aboard NASA’s Europa Clipper, ASU’s E-THEMIS device took an infrared photo of the surface of Mars. Scientists will study it for signs it could support life.




Many industries rely on ultra-pure water, such as semiconductor, battery, pharmaceutical, and food and beverage companies.
Producing pure water requires desalination systems like reverse osmosis, but these processes leave behind a salty byproduct called brine. Managing brine is costly and creates environmental challenges, especially in landlocked regions such as Arizona, where it cannot be released into the sea.
ASU, in partnership with Nestlé, is addressing this issue through a demonstration project supported by the Arizona Water Innovation Initiative and the Global Center for Water Technology. The research team is developing a mobile, closed-loop water recovery system designed to squeeze more usable water from industrial brine while reducing waste.
The goal is to recover 50%–90% of water that would otherwise be discarded and turn most of the remaining waste into manageable salt solids.
For Nestlé’s Arizona facility, which produces more than 50,000 gallons of brine daily, this approach could greatly reduce the number of tanker trucks needed to haul waste off-site. It also lowers the burden on wastewater treatment plants and irrigation systems affected by high salinity. By recovering water that would be lost and reducing liquid waste, the system supports both economic efficiency and environmental sustainability.


Earth’s continents are losing fresh water at alarming rates, according to a new global study led by ASU. The study calls for immediate action to slow and reverse groundwater loss, protect freshwater resources, and adapt to the growing risk of water scarcity and coastal flooding. Strategic water management, international cooperation and sustainable policies are essential to safeguard water for communities and future generations.
that dry areas are drying out faster than wet areas are getting wetter. Three out of four people live in countries that have lost fresh water for more than two decades.
Researchers found that most of this loss comes from groundwater, which accounts for 68% of the decline. Groundwater loss is also accelerating sea-level rise — in fact, it is a bigger contributor than melting glaciers and ice caps on land.
ASU and Nestlé aim to use the facility to give hands-on training to students from nearby community colleges, as well as upskilling opportunities for Nestlé employees, to prepare an equipped local workforce.
Brine recovery could also hold additional opportunities. Concentrated brine could be a source of valuable minerals like lithium, magnesium or potassium. Although the technology needed is costly, industry has shown interest in the potential investment.
The ASU-Nestlé partnership demonstrates how industry and academia can address urgent water challenges together. It also provides a framework that could be applied in other regions facing similar salinity issues, ensuring that fewer resources are wasted and more water is put to good use.
Using 22 years of satellite data, ASU researchers found that land around the world has been drying rapidly, with four massive “mega-drying” regions emerging in the Northern Hemisphere. These regions include the American Southwest and Central America, Alaska and Northern Canada, Northern Russia, and the Middle East-North Africa Pan-Eurasia region.
The drying is linked to climate change, unsustainable groundwater use and extreme drought. The study reveals that dry
The findings highlight a tipping point around 2014–15 when climate extremes and overuse of groundwater caused continental drying to accelerate. The study warns that without urgent action, food and water security for billions of people could be at risk.
The research underscores the importance of longterm monitoring and international cooperation. Better groundwater management, new policies and sustainable practices can help slow drying, protect freshwater supplies


of Americans think the quality of the environment in the country as a whole is getting worse.

In the Ecuadorian Amazon, ASU professors partnered with Indigenous communities to design solarpowered canoes and charging stations.
In the U.S. Southwest, an ASU researcher is working with the Native-led Colorado Plateau Foundation to protect environments and preserve cultures across tribal lands.
In the Southwest, water determines whether communities thrive or decline. It supports human health, farming, electricity, tourism and now, growing industries like semiconductor manufacturing and data centers. The NSF Futures Engine in the Southwest, led by ASU, launched a strategic initiative to secure the region’s water future through innovation in atmospheric water harvesting, scaling industrial reuse and reducing water consumption in high-demand facilities.
• Supported by the Futures Engine, startup WAVR Technologies developed devices that pull moisture from the air for commercial and industrial use. Their system produces over five times more water than previous methods and works even in very dry conditions. In its first year, WAVR built a prototype and raised more than $10 million in funding.
• The engine worked with semiconductor giant TSMC to expand water reuse, securing more than $1.7 million in funding from state and federal sources.
• Regional testbeds at ASU are evaluating atmospheric water harvesting devices from six startups under real-world conditions.
• Other supported companies include GlycoSurf, which purifies water and recovers rare earth minerals from industrial waste using biodegradable extractants, and Purity ReSource, which is reducing water waste in semiconductor production with new membrane technology that fits into existing equipment.
Together, these efforts are creating practical solutions that protect water supplies, reduce industrial waste, reclaim valuable resources and build resilience across the Southwest.

A new algae-based system helps Arizona farmers grow healthier crops while saving water and improving soil quality. ASU and MyLand, a Phoenix-based company, demonstrated how this soil health system can drive measurable water conservation at a southern
“What we’re really talking about is how can we keep agriculture productive, even in the face of less water? Which is what we’re facing here in this county. So, there’s a lot of different ideas, a lot of different solutions. ... I’m really excited to see these kinds of efforts.”
Paul E. Brierley Director, Arizona Department of Agriculture

Arizona farm this summer. The system grows live, native microalgae in special tanks on site and then injects it directly into the farm’s irrigation system. The algae improves the soil’s health and enhances its ability to hold water, allowing crops to withstand longer dry spells.
This innovation comes at a critical time, as Arizona farmers face hotter temperatures, less reliable rainfall and ongoing water shortages. By using the algae additive, farmers can reduce their irrigation while keeping crop yields high. The project has already shown promising results in test fields growing chile peppers, alfalfa and pecans.
Thanks to a grant administered through the Water Infrastructure Finance Authority of Arizona, the collaborative project will provide free access to this nature-based soil health technology across thousands of acres of Arizona’s commercial farmland.



ASU received a $115 million gift from the Rob Walton Foundation, the largest in the university’s history, to create the Rob Walton School of Conservation Futures. The new school will train the next generation of conservation scientists and corporate leaders to protect biodiversity and natural resources worldwide. It will offer scholarships, professional development programs and research opportunities for students, educators and industry experts. By combining hands-on learning with advanced science, the school will help communities, governments and businesses develop solutions for climate challenges and sustainable resource use. The gift will also strengthen global partnerships, creating scalable strategies that connect local conservation efforts with global environmental goals for a healthier, more sustainable planet.


“Students bring fresh ideas, energy and innovation. They’re the next generation of leaders, researchers and advocates. By getting involved now — through research, advocacy or fieldwork — they gain the skills to drive real change. We need their voices and commitment to sustain a healthy planet.”
Rob Walton Philanthropist, Conservationist and the former Chairman of Walmart



Six years ago, scientists around the world launched an ambitious project to map the DNA of all the animals, plants, fungi and other complex organisms on the planet — more than 1 million species in total.
The Earth BioGenome Project is a collaborative, international effort coordinated at ASU. The project has already sequenced more than 5,000 species’ genomes.
The massive DNA sequencing project will yield enormous benefits for people and the planet. Scientists hope to unlock new knowledge that will lead to life-saving medicines, better crops, new biomaterials
for manufacturing and genetic resources to rebuild threatened ecosystems. Many modern drugs already come from natural compounds found in plants and animals, and researchers believe many more remain undiscovered. Mapping DNA will also deepen our understanding of how life evolved, how ecosystems function and how to preserve endangered species before they disappear.
Advances in technology have made this once impossible project faster and more affordable. What once cost billions of dollars can now be done for a few thousand per genome. ASU contributes key resources, including a national biorepository that holds
more than 800,000 biological samples collected from across the U.S., providing crucial data for sequencing and conservation. ASU researchers are focusing on desert species to learn how they adapt to heat and drought, information that could help humans and crops survive in hotter climates.
A record of Earth’s genetic diversity offers powerful tools for medicine, agriculture and environmental protection while preserving the biological blueprint of life for future generations.
ASU researchers discovered fossils of a new ancient human relative, as well as evidence that it lived side-by-side with the earliest species of our own lineage, Homo.

This finding reshapes how scientists understand human evolution, showing that our ancestry was not a straight line from primitive apes to modern humans but a branching network of species that evolved, adapted and sometimes disappeared. Ancient hominins’ responses to environmental changes — adaptation or extinction — hold lessons for us today as we try to steward natural resources and build resilient communities and ecosystems.
Researchers found 13 fossilized teeth at the Ledi-Geraru site in northeastern Ethiopia. They were a mix that belonged to both early Homo and a newly identified species of Australopithecus. The new species is different from that of the famous Lucy fossil — Australopithecus afarensis — which disappeared earlier in the paleontological record.
The teeth were preserved between volcanic ash layers that geologists could date precisely. Scientists confirmed the teeth are between 2.6 and 2.8 million years old. Other fossil and geologic evidence from this time indicate that this region was a lush, dynamic environment where ancient rivers and shallow lakes supported a variety of life.



As scientists continue to uncover fossils and analyze their context, the picture of human evolution grows richer and more complex. But these insights also hold lessons for today. Understanding how early humans adapted to environmental stress may offer clues for how we can face nature’s current challenges. For early hominin species, survival often depended on cooperation, flexibility and innovation. If the pattern holds true, modern society’s progress will likewise depend on our ability to adapt.

New Global Institute for the Future of Energy
Funded by a philanthropic gift from Bob Zorich, the Global Institute for the Future of Energy will lead the way in energy education and innovation, helping people and organizations navigate and better understand complex energy issues.
The institute — a collaboration between the Julie Ann Wrigley Global Futures Laboratory® and Thunderbird School of Global Management at ASU — will expand access to energy information and develop practical solutions that advance global energy systems while supporting human flourishing.

Repairing bridges, roads and railways often takes months, costs millions, and disrupts traffic and communities — but ASU is changing that.
Engineers are transforming Arizona infrastructure with new types of concrete that can bring a six-month road repair down to 10 days, at a fraction of the cost.
Working with the Arizona Department of Transportation, ASU researchers created nonproprietary mixtures of ultra-high-performance concrete. Their mixtures use local materials and outperform regular concrete in strength and durability. They resist cracking, corrosion and fatigue, meaning repairs last longer and cost less over time.
For Maricopa County, which was struggling with deteriorating slab bridges, ASU’s team provided locally sourced solutions at a fraction of the previous cost and trained local workers to apply them. The county can now use the funding for one bridge repair to fix multiple bridges, saving taxpayers significant money.
The impact extends beyond roads and bridges. For Valley Metro’s light rail extension, ASU proposed replacing traditional rebar with fiber-reinforced concrete, which is quicker to install and less prone to corrosion. Testing showed that fibers inside the concrete act like tiny Band-Aids, stopping cracks from spreading and extending the material’s lifespan. This reduces construction time, lowers costs and improves long-term reliability for public transit. It’s also much safer for workers to install.
These concrete innovations not only improve safety and resilience but also bring in federal funding opportunities tied to advanced materials. By combining scientific expertise with hands-on collaboration, ASU is helping Arizona strengthen its infrastructure, minimize traffic disruptions and stretch limited budgets further.


A team of researchers from Arizona’s three public universities is creating analytic models designed to identify early factors associated with homelessness. Ultimately, the team hopes to connect service providers with people most likely to experience homelessness before they lose their homes.
The Arizona Housing Analytics Collaborative, co-founded by an ASU researcher, brings together ASU, the University of Arizona and Northern Arizona University to study early signs of housing insecurity. By identifying warning factors early, service providers can connect people with financial support or housing resources before eviction occurs.
Preventing homelessness not only saves families from the anguish of housing uncertainty, but also can save tax dollars. Studies show it costs much less to help people at
risk than to support those who have already lost housing.
For a year, researchers interviewed service providers working in encampments and the residents who live in them across Maricopa, Pima and Yuma counties. Early results show that most people living in encampments want housing and jobs to stabilize their lives. Many also form tight-knit communities, though their interactions with law enforcement can be challenging.
While many strategies have been tried to reduce encampments, there is little evidence about which ones work best. The collaborative addresses this gap by sharing data and insights directly with local and state agencies, helping policymakers make informed decisions.
By combining technology, research and human experience, Arizona’s universities are creating a system that improves housing stability, guides smarter investments and builds a foundation for reducing homelessness across the state and beyond.

7.2M
U.S. households spend 50% or more of their income on housing costs, putting them at risk of homelessness.
National Alliance to End Homelessness, “State of Homelessness: 2025 Edition”
Partnership

Adding renewable energy to the electrical grid can make it more reliable and less expensive.
What was once thought impossible is now a proven reality thanks to an ASU team’s smart energy grid management system.
Their project, Providing Energy Resilience With an ROI, demonstrated that this smart control software saved money and improved performance at
“ASU’s work helps SRP better understand how microgrids interact with our distribution system and what capabilities could benefit the rest of our customers.”
Joel Dickinson Senior Manager of Distribution Integration, Salt River Project
a facility operated by the Arizona Department of Emergency and Military Affairs.
The software system, known as Adaptive Control of Energy Systems, works like a digital “brain” that coordinates power across a microgrid of onsite solar panels, batteries and backup generators. It decides when to use or store energy for maximum efficiency. During testing, the site’s utility bills dropped by up to 40%. Performance improved by 22% during simulated power outages, keeping electricity running a full day longer than if the site relied on backup generators alone.
ACES was developed with support from the Department of Defense. The software integrates easily with existing systems, meaning military bases and other microgrid users can avoid major upgrades or replacements. It also allows facilities to manage their energy independently and reduce strain on the larger utility grid.
The research benefits students as well, giving them hands-on experience in designing and implementing real systems. Students played key roles in testing, software development and data analysis, gaining practical skills for careers in energy technology.
The potential of this smart energy control software prompted utility provider Salt River Project to get involved. SRP plans to apply lessons from ASU’s work to its own microgrid research, which could improve grid management for customers across the state. Beyond saving money and reducing emissions, the technology could help communities, businesses and military bases maintain stable power during emergencies.
The successful ACES demo illustrates how ASU research can directly enhance energy efficiency, strengthen infrastructure, and make sustainable power more affordable and dependable for everyone.
in action
Optimized indoor lighting can significantly improve sleep and mood for people with dementia, according to a new ASU study.
The research, conducted at a Tempe, Arizona memory-care facility, tested biodynamic lighting that mimics the natural rhythm of daylight — bright and blue-toned in the morning, neutral in the afternoon, and warm and dim in the evening. Using biodynamic lighting, 10 older adults with dementia experienced nearly 90 minutes more sleep per night and fewer symptoms of depression and agitation.
This lighting system helps align the body’s circadian rhythm, the internal clock that regulates sleep, mood and alertness. Because dementia often disrupts this rhythm, many patients experience poor sleep, which worsens cognitive and emotional health. By replicating daylight cycles indoors, the biodynamic lights restored a sense of day and night, helping residents feel calmer and more rested. Caregivers reported that participants enjoyed the lights so much, they tried to turn them on themselves after the study ended.
The researchers launched a startup for an AI-based adaptive lighting system that automatically adjusts intensity and color based on an individual’s biological signals, preferences and daily schedule. This approach could further support cognitive health and slow decline in people with dementia.





The temperature of a living space can also affect productivity and relaxation. When the researchers combined light and temperature settings, they found that men performed best with cooler temperatures and cool light, while women did better with warmer settings. The gender gap was wider among older adults. Care facilities and hospitals could use these insights to improve residents’ well-being. An AI system, for example, could customize indoor environments to each person’s unique needs.
By bringing science-based design into real-world care settings, ASU’s research demonstrates how something as simple as light can enhance quality of life, reduce caregiver burden, and help older adults live more comfortably and independently.

Robots at your service
ASU researchers are developing robots that can safely assist with tasks like household chores or medical care by teaching machines how to learn, adapt and understand humans.




of Arizonans agree it is important to increase spending and measures to prevent forest fires on state land.
ASU engineering researchers created a new system to detect and prevent wildfires before they spread.
The project, called Wildfire Awareness and Risk Management (WARM), uses smart sensors and power-grid optimization to reduce fire damage, save lives and prevent widespread power outages. It was developed as part of a collaboration between ASU and the University of Wisconsin-Madison.
millions without electricity. The ASU system instead focuses on local weather data around specific power lines. If sensors detect fire risk, utilities can reduce power on just those lines instead of shutting all of them off entirely. This balance keeps communities safe while keeping the power on for most customers.


Fido’s feelings
ASU scientists found that people misread their dogs by projecting human emotions and focusing on situational context. Attention to your pup’s cues can help you understand him better.
The idea for WARM came after a downed power line triggered the deadly 2018 Camp Fire, which destroyed the town of Paradise, California. The ASU team designed a layered sensor system that monitors humidity, wind and temperature around remote electric power infrastructures where wildfires often start. When the sensors detect dangerous conditions, they activate secondary sensors to check for smoke or gases before turning on thermal cameras. This targeted approach conserves battery life while allowing early detection of fires.
WARM also addresses the fire risks posed by the electrical grid. Traditionally, utilities employ a system that preemptively disconnects power if conditions are ripe for a fire. This reduces the chance of wildfire but can leave
The team’s computer simulations show that the system can prevent widespread blackouts while reducing potential wildfires to just a few manageable incidents. Supported by a $1.5 million National Science Foundation grant, WARM represents a major step toward safer, more resilient energy systems.
The WARM system is currently operational and ready to be commercialized and put to use in our communities. In the future, the sensor suites and risk management approaches developed through this project could have broader impacts in disaster mitigation, environmental monitoring and public safety.
Indigenous languages around the world are disappearing at an alarming rate, with the United Nations estimating that a language goes extinct every two weeks.
When a language is lost, we lose more than words — each one carries cultural values, oral histories, ecological knowledge, and a sense of home and belonging. Language preservation is essential to community well-being as well as maintaining traditions.
That’s why ASU linguists are working with Native American communities to document, preserve and revitalize endangered Indigenous languages across the Southwest.
The researchers collaborate with tribal nations including the Fort McDowell Yavapai Nation, the Salt River Pima-Maricopa Indian
Community, the San Carlos Apache Tribe and the Pueblo of Santa Ana. These partnerships are communityled, with projects guided by their priorities, such as building oral history archives, creating teaching materials or co-authoring scholarly work. One outcome is a new writing system for Tamayame, the language spoken in the Pueblo of Santa Ana, New Mexico, of which there are less than 100 living speakers.
Another focus of this work is to train students for meaningful work in language revitalization. Graduate and undergraduate students are helping record and analyze Indigenous languages, building valuable professional skills while contributing to tribal sovereignty and education.
By combining linguistics and community engagement, this research ensures endangered languages — and the precious knowledge they carry — are passed to future generations.

A collaborative effort to remove carbon dioxide from our atmosphere and invest in the local workforce received $11.2 million from the U.S. Department of Energy, with matching funds from industry partners. The ASU-led collaboration brings partners across industry, academia and government to create a resilient energy economy in the Southwest.


The grant will fund the design of three sites that form a regional Direct Air Capture Hub in the Four Corners area. These sites will use new technologies to capture at least 1 million metric tons of carbon dioxide from the air each year and store it away. The effort will also generate new, high-paying jobs in communities affected by coal plant closures.
A leader in litter
An ASU alumna and chemist co-invented Fresh Step Kitty Litter (patented in 1983), a breakthrough pet product that’s still keeping homes fresh.


of Arizonans agree that a highly educated and skilled population is good for Arizona’s economy.
Gallup,
ASU’s SolarSPELL Initiative — which provides solar-powered digital libraries to communities without internet access — has been named one of TIME’s Best Inventions of 2025 in the “social impact” category.
The recognition honors SolarSPELL’s decade-long work bringing education, health and sustainability resources to remote regions around the world while offering ASU students transformative learning experiences.
SolarSPELL, short for Solar Powered Educational Learning Library, began as a class engineering challenge to build a portable, solar-powered device that could store and share educational materials offline. Today, the project is a global operation with more than 600 devices deployed across 15 regions, including Africa, the Pacific Islands and tribal communities in the United States.
Each compact library, built to fit in a backpack, creates a Wi-Fi hotspot powered entirely by the sun. Anyone within range can access its locally curated content on a phone, tablet or laptop — without needing an internet connection.
Students are central to SolarSPELL’s innovation. They design, test and refine the devices to make them more lightweight, durable and reliable. Students recently helped



with a design update that made the libraries more resistant to heat, dust and water.
The libraries are adapted to different cultures and languages depending on the communities they will serve. Students curate materials on topics such as farming, health care and education, ensuring each device meets local needs. To determine those needs, SolarSPELL works with local partners in each region, such as the Peace Corps and government ministries.
SolarSPELL’s reach continues to grow. In Rwanda, it partners with Bridge2Rwanda Farms, which teaches small-scale farmers how to increase crop yields through climatesmart farming methods. Together they deployed 70 libraries and trained 100,000 farmers in sustainable agriculture. Farmers who learned about conservation agriculture through SolarSPELL saw a 56% increase
in maize yield and were more likely to share their knowledge with other farmers.
In Ethiopia, the initiative works with the United Nations Refugee Agency to bring libraries to schools in refugee camps.
Closer to home, SolarSPELL partnered with HOPI Cancer Support Services and an ASU nursing student who is a member of the Hopi Tribe to provide devices with culturally relevant information for people with cancer.
By using renewable energy and openaccess learning, SolarSPELL helps schools, clinics and communities access vital information without reliance on costly infrastructure. For students, it provides an opportunity to use their creativity to solve pressing social problems and make a lasting global impact.

People can’t be healthy if the soil, air and water around them are unhealthy.
Scientists study the chemicals present in an area to learn how people may be affecting the environment and whether any changes pose a risk to the health of communities nearby.
ASU students are getting the chance to do this impactful work themselves. Their fieldwork for an environmental chemistry course is helping protect the Hassayampa River Preserve and nearby town of Wickenburg, Arizona. Working with Maricopa County and The Nature Conservancy, the class gathers data to track the preserve’s health and guide protective efforts.
The 770-acre preserve is home to hundreds of bird species and a unique desert river ecosystem, but it faces growing threats from runoff, wildfire damage and low oxygen levels in its waters. The site lacked consistent environmental monitoring, so ASU students are filling that gap by collecting and analyzing water, soil and vegetation samples each spring. Their studies measure metals, nutrients and other indicators of pollution while exploring how fire, drought and human activity affect ecosystem balance.
of Arizonans agree that it is important to preserve and protect Arizona’s rivers, natural areas and wildlife.
Gallup, Center for the Future of Arizona, “The Arizona We Want,” 2021


Students use professional research tools through ASU’s Core Research Facilities to test samples and analyze chemical composition. Their findings are shared with Maricopa County to guide conservation strategies and reduce contamination risks. The class not only generates valuable environmental data but also trains students in fieldwork, scientific analysis and community collaboration. Projects have included tracking metals left by past mining operations, studying the effects of wildfire on soil health and analyzing tree rings to understand historic environmental changes.
This unique course helps local agencies make informed decisions to preserve the Hassayampa River for future generations. It also prepares students to become scientists, environmental leaders and problem-solvers capable of protecting Arizona’s natural resources.
AI technology could soon help people with vision loss navigate the world more safely and independently, thanks to an ASU computer science master’s student. Working in ASU’s Laboratory for Learning Evaluation of autoNomous Systems (LENS), she designs AI-powered assistants for smart glasses, such as Ray-Ban Meta AI Glasses, to help users interpret their surroundings.
Smart glasses can already capture photos and video, recognize common objects in them, and combine digital information with real-world images. The LENS Lab project combines these existing features with new features specially designed to assist those with visual disabilities.
As the smart glasses collect images, the wearer can speak questions aloud, asking for more details. A person might ask the AI assistant how many steps of a staircase are ahead, or to identify an object off in the distance or read the text of a street sign.

Children who need a motorized wheelchair have to pass a driving test before they can receive one. But training wheelchairs can cost thousands of dollars. ASU students created low-cost motorized training wheelchairs to help children ages 4 to 7 learn how to drive safely. The task was part of the Health Care Innovation Design Challenge, created through a partnership between ASU and The Mobility Independence Foundation.
The open-source designs cost less than $500 to build and use easily available materials like booster seats, PVC piping and children’s ride-on-car parts. These affordable prototypes could help families worldwide, especially in low-income communities, by improving children’s mobility and independence. Meanwhile, participating students gained valuable experience in creative engineering and problem-solving for social good.


ASU scientists completed a series of experiments on the compact X-ray light source (CXLS) — the first of two X-ray instruments for the CXFEL — to solve a protein structure and establish the tool’s ability to study matter.

Workforce development
Students are gaining life-changing research experience working with ASU’s compact X-ray free electron laser (CXFEL), a world-class scientific facility located in the Biodesign Institute’s underground lab. As the first of its kind in the world, the project offers a unique opportunity to train students on state-of-theart technology that will usher in new insights into biology, bioenergy and drug development.
Students from physics, engineering, computer science and other disciplines are deeply involved in the design, construction and testing of the multimillion-dollar facility. They collaborate with faculty mentors, scientists and engineers to build and refine the instruments that generate high-intensity X-rays capable of imaging molecules in motion. Through this work, students are mastering skills in precision engineering, data analysis and advanced software modeling, preparing them for careers in research, technology and industry.







Research is a stepping stone toward the future we envision and the goals we share. It creates solutions that serve our communities and the world.” “

Sally C. Morton Executive Vice President ASU Knowledge Enterprise


Lab Coat Optional is the show where research is made relatable. You’ll learn what elephants can teach us about treating cancer, why a tribe in the Amazon excels at aging well, what you didn’t know about the rebel author Jane Austen and much more.
Learn more at:
labcoatoptional.asu.edu



research.asu.edu

01/2026 Since 2020, ASU printing practices led to 4M+ pounds of paper offset and 51K+ trees reforested
